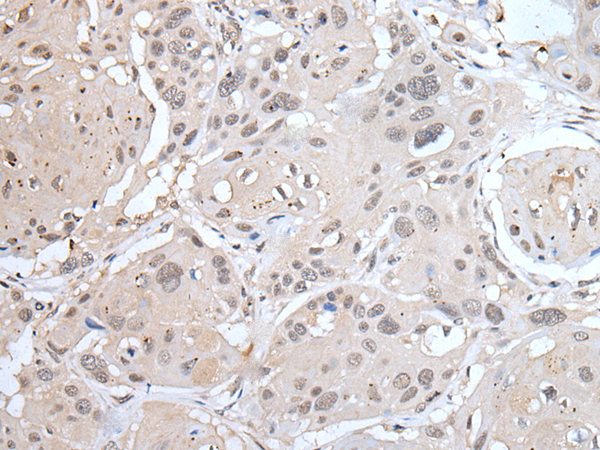

技術規(guī)格
Background:
The leucine-rich (LRR) repeat is a 20-30 amino acid motif that forms a hydrophobic /∫ horseshoe fold, allowing it to accommodate several leucine residues within a tightly packed core. All LRR repeats contain a variable segment and a highly conserved segment, the latter of which accounts for 11 or 12 residues of the entire LRR motif. The primary function of these motifs is to provide a versatile structural framework to mediate the formation of protein-protein interactions. LRRs are present in a variety of proteins with diverse structure and function, including innate immunity and nervous system development. Several human diseases are associated with mutations in genes encoding LRR-containing proteins. LRRC23 (leucine-rich repeat-containing protein 23), also known as leucine-rich protein B7, is a 343 amino acid protein that contains eight LRR (leucine-rich) repeasts and one LRRCT domain. LRRC23 exists as two alternatively spliced isoforms and is encoded by a gene mapping to chromosome 12.
Applications:
ELISA, IHC
Name of antibody:
LRRC23
Immunogen:
Synthetic peptide of human LRRC23
Full name:
leucine rich repeat containing 23
Synonyms:
LRPB7
SwissProt:
Q53EV4
ELISA Recommended dilution:
5000-10000
IHC positive control:
Human thyroid cancer and human esophagus cancer
IHC Recommend dilution:
25-100

購物車
幫助
021-54845833/15800441009
